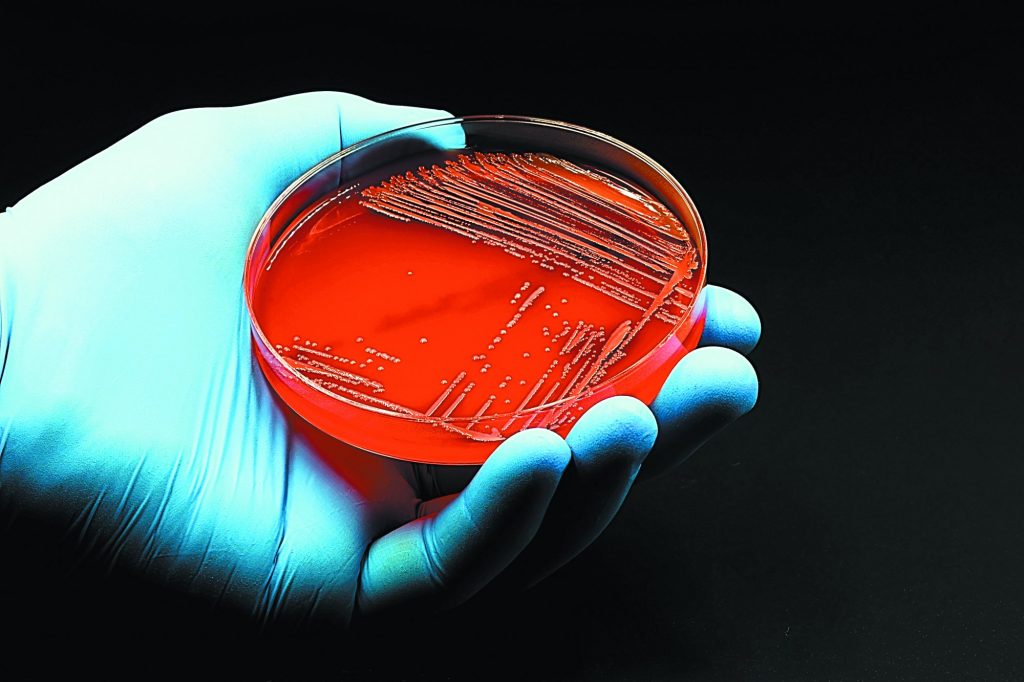
Τοξικό άγαρ σκοτώνει βιοϊατρικά πειράματα σε όλο τον κόσμο

Μολυσμένες παρτίδες ενός υλικού που χρησιμοποιείται ευρέως στη βιοϊατρική έρευνα έχουν παραδοθεί σε εργαστήρια σε όλο τον κόσμο, χωρίς να είναι δυνατόν να εντοπιστούν αναδρομικά, προειδοποιούν ερευνητές που έχασαν ολόκληρους μήνες δουλειάς.
Δύο ανεξάρτητα εργαστήρια στις ΗΠΑ και στη Γαλλία αναφέρουν με άρθρο τους στο αποθετήριο «bioRxiv» ότι υπέστησαν σοβαρές ζημιές από μολυσμένο άγαρ, μια ζελατινώδη ουσία που χρησιμοποιείται ως υπόστρωμα για την καλλιέργεια μικροοργανισμών σε τρυβλία Πετρί (εικόνα).
Το τοξικό άγαρ σκότωσε όλες τις καλλιέργειες ζυμομυκήτων, όμως η ουσία στην οποία οφείλεται η τοξικότητα παραμένει άγνωστη, είπαν οι ερευνητές.
Οπως επισήμαναν, το ίδιο πρόβλημα εμφανίστηκε σε αρκετά ακόμα εργαστήρια που είχαν προμηθευτεί άγαρ από άλλες εταιρείες σε διαφορετικές χώρες.
Ειδικοί σχολίασαν ότι η πηγή της μόλυνσης ίσως είναι πρακτικά αδύνατο να εντοπιστεί, δεδομένου ότι το άγαρ παράγεται από διάφορα είδη ροδοφυκών, τα οποία συλλέγονται στην ανοιχτή θάλασσα και η ποιότητά τους γενικά δεν ελέγχεται. Και το γεγονός ότι διαφορετικές εταιρείες συσκευάζουν άγαρ από τους ίδιους προμηθευτές ίσως συνετέλεσε στην παγκόσμια εξάπλωση του προβλήματος.
Προς το παρόν, η μόνη λύση για τα εργαστήρια που δουλεύουν με ζυμομύκητες είναι να πραγματοποιούν δοκιμαστικές καλλιέργειες πριν προχωρήσουν σε σημαντικά πειράματα. Στο καλύτερο δυνατό σενάριο, πάντως, το τοξικό άγαρ ίσως οδηγήσει στην ανακάλυψη κάποιου νέου, πολύτιμου μυκητοκτόνου.